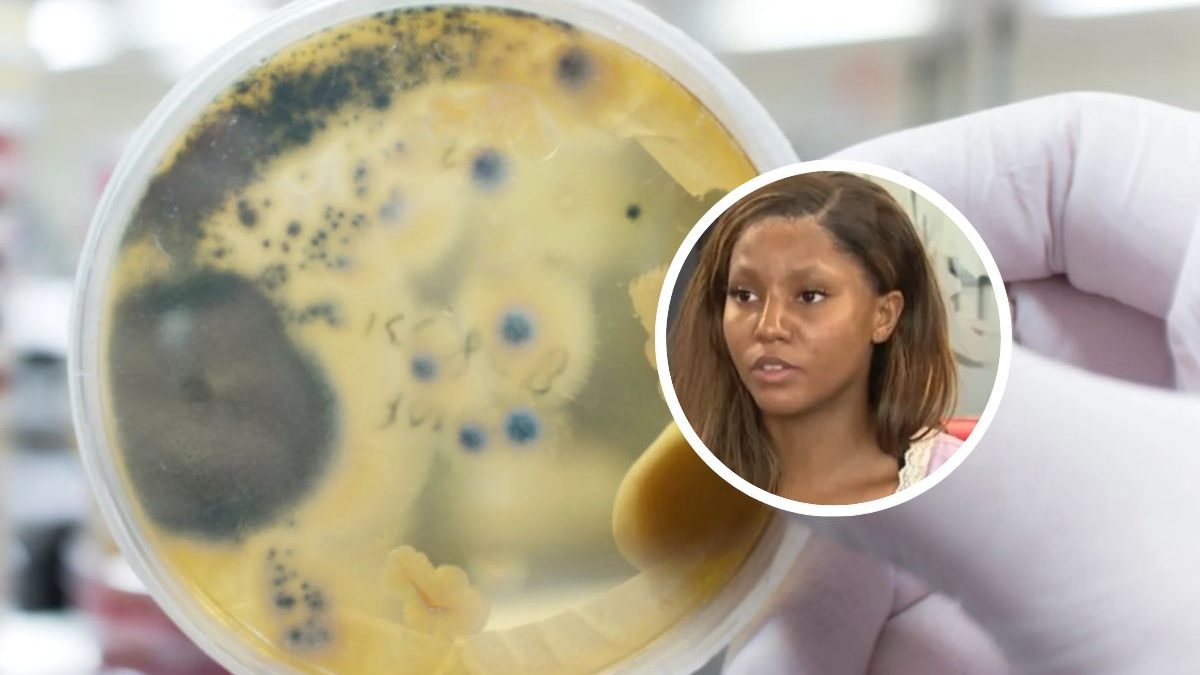

Cinco pessoas morreram após contraírem uma super bactéria; caso de jovem atleta em Michigan acende alerta sobre os riscos da doença
Cinco pessoas já foram vítimas de uma bactéria comedora de carne nos Estados Unidos – Foto: Reprodução/La cara Buena del Mundo/NDCinco pessoas morreram na Louisiana, nos Estados Unidos, após contrair uma bactéria comedora de carne, segundo o CDC (Centro de Controle e Prevenção de Doenças).
O órgão informou que a infecção pode causar doenças graves, como necrose, com risco elevado de morte.
De acordo com os dados, cerca de uma em cada cinco pessoas infectadas pela bactéria Vibrio vulnificus não sobrevive. As autoridades ainda investigam a forma de contaminação. Segundo o UOL, uma atleta de natação se contaminou ao nadar em uma piscina de hotel.
A bactéria pode entrar no corpo através de feridas expostas à água contaminada ou pela ingestão de frutos do mar crus ou malpassados. O departamento de saúde da Louisiana informou que duas das mortes registradas neste ano tiveram ligação com o consumo de ostras cruas contaminadas.
A Louisiana não é o único estado a registrar ocorrências. Segundo autoridades, já foram confirmados 10 casos de Vibrio vulnificus no Alabama e três no Mississippi, com uma morte confirmada neste último estado. O aumento de diagnósticos acendeu o alerta em diferentes regiões do sul dos Estados Unidos.
A atleta Alexis Williams, de 23 anos, revela o drama após contrair a doença – Foto: Reprodução/NDAtleta contrai bactéria comedora de carne em piscina de hotel
Além dos casos na Louisiana, um episódio recente envolvendo a atleta Alexis Williams, de 23 anos, chamou atenção em Michigan. A jovem contraiu uma superbactéria resistente a antibióticos, conhecida como MRSA, após mergulhar em uma piscina de hotel no fim de junho.
De acordo com os relatos, a atleta sofreu apenas um arranhão dentro da piscina, mas em 24 horas começou a sentir dores intensas no local. No hospital, recebeu o diagnóstico de que havia sido infectada pela bactéria comedora de carne, capaz de corroer tecidos humanos.
Superbactéria é responsável por corroer tecidos da pele humana – Foto: Edward Jenner/Pexels/Reprodução/NDSegundo o UOL, Alexis Williams já passou por três cirurgias desde a descoberta da infecção e conseguiu se recuperar, mas ainda depende da ajuda da mãe para se locomover.
A família de Alexis acusa o hotel Residence Inn, em Michigan, de falhar na manutenção da piscina. De acordo com os parentes da atleta, inspeções apontaram que a água do local não possuía cloro.
O caso repercutiu na imprensa norte-americana, mas o hotel afirmou à emissora CBS News Detroit que não irá se pronunciar publicamente sobre as acusações.